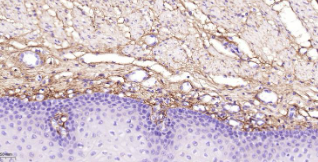

Human Collagen III Ready-To-Use IHC Kit
Human Collagen III Ready-To-Use IHC Kit
Cat. No.: IHC0655HSample Type: FFPE tissue
Size: 50T (including a control slide)
Storage and Stability: Please store components at the temperatures indicated on the individual tube labels. The kit is stable for 6 months from the date of receipt.
Background
Collagen III is a fibrillar collagen that is found in extensible connective tissues such as skin, lung, and the vascular system, frequently in association with type I Collagen. Mutations in th gene are associated with Ehlers Danlos syndrome type IV, and with aortic and arterial aneurysms. Although alternate transcripts have been detected for this gene, they are the result of mutations; these mutations alter splicing, often leading to the exclusion of multiple exons.
Synonyms
COL3A1; EDS4A; CO3A1; Collagen alpha 1(III) chain; Collagen III alpha 1 chain precursor; Collagen type III alpha 1.Validation Data
Materials Supplied
| Number | Component | 50T | Concentration | Storage |
|---|---|---|---|---|
| 1 | PBS Buffer (powder) | 2L x 2 | 20x | RT |
| 2 | Antigen Retrieval Buffer | 20ml | 100x | 2-8°C |
| 3 | Endogenous Peroxidase Blocking Buffer | 3ml | RTU | 2-8°C |
| 4 | Blocking Buffer | 3ml | RTU | 2-8°C |
| 5 | Primary Antibody (Human Collagen III Mouse mAb) | 6ml | RTU | 2-8°C |
| 6 | Secondary Antibody (AffiniPure Goat Anti-Mouse IgG H&L, HRP conjugated) | 6ml | RTU | 2-8°C |
| 7 | Chromogen Component A | 0.3ml | RTU | -20°C |
| 8 | Chromogen Component B | 0.3ml | RTU | -20°C |
| 9 | Counter Staining Reagent | 5ml | RTU | RT |
| 10 | Differentiation Reagent | 6ml | RTU | RT |
| 11 | Mounting Media | 5ml | RTU | RT |
| 12 | Control slide (Human prostate) | 1 slide | RTU | RT |
| 13 | Datasheet | 1 copy |
Notes
- The positive control slide provided in the kit allows you to be sure that the experimental set-up is working properly.
- Do not allow slides to dry at any time during this procedure.
- Please don't replace the matching reagents in this product with other manufacturers' products.
- As DAB is a carcinogen, please take necessary precautions.
- PBS (reagent 1) can be stored for one week at 4℃ after preparation; The antigen retrieval buffer (1×reagent 2) and the chromogenic agent (the mixture of reagents 7 and 8) should be prepared right before each assay.
As DAB is a carcinogen, please take necessary precautions.
Important Note: This product as supplied is intended for research use only, not for use in human, therapeutic or diagnostic applications.